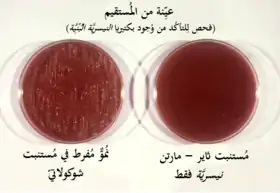

نيسرية بنية
النَيْسَرِيّة البُنِّيّة (الاسم العلمي: Neisseria gonorrhoeae) هي نوع من البكتيريا تتبع جنس النيسرية من فصيلة نظيرات النيسرية.[1] وهي بكتيريا سلبية الغرام ذات شكل كلوي ومزدوجة التكور، وتسبب مرض السيلان.[2]
اضغط هنا للاطلاع على كيفية قراءة التصنيف النيسرية البنية | |
|---|---|
![]() نيسرية بنية مستزرعة في وسطين مختلفين | |
| المرتبة التصنيفية | نوع |
| التصنيف العلمي | |
| النطاق: | بدائيات النوى |
| المملكة: | بكتيريا |
| الشعبة: | المتقلبات |
| الطائفة: | متقلبات بيتا |
| الرتبة: | النيسريات |
| الفصيلة: | نظيرات النيسرية |
| الجنس: | النيسرية |
| النوع: | نيسرية بنية |
| الاسم العلمي | |
| Neisseria gonorrhoeae (Zopf) Trevisan، 1885 | |
وأول من وصف النيسرية البنية هو ألبيرت نيسر عام 1879.
وصف البكتريا
النيسرية بكتريا مرهفة غير مقاومة للعوامل الخارجية كالجفاف والبرودة لها احتياجات تغذوية واستزراعية معقدة، وهي تنمو على غراء الشكولاتة مع ثاني أكسيد الكربون بشكل خاص. والمكورات النيسيرية هي بكتريا مزدوجة داخل خلوية.
عادة ما يتم عزل النيسرية على غراء ثاير-مارتن وهو عبارة عن أغار يحتوي على ثلاث أنواع مختلفة من المضادات الحيوية ومواد مغذية، وتعمل المضاد الحيوية على تثبيط نمو بكتريا موجبة الغرام والفطريات. وتحتوي كل أنواع النيسرية على إنزيم الأوكسيداز ويتم التفريق بين الأنواع عن طريق اختبار الكربوهيدرات والذي يشمل على الجلوكوز والمالتوز والسكروز حيث النيسرية البنية تأكسد الجلوكوز فقط.
النيسرية البنية قادرة على سحب أجسام تفوق وزنها ب100,000 مرة ويعتقد أن شعيرات النيسرية هي أقوى محرك بيولوجي معروف.[3]
الأمراض
مقالة مفصلة: سيلان (مرض)
أعراض العدوى بالنيسرية البنية تختلف باختلاف مكان الإصابة. التهاب الأعضاء التناسلية يؤدي إلى خروج إفرازات قيحية كريهة الرائحة من الأعضاء التناسلية. كما قد يصاحب ذلك إحمرار الأعضاء التناسلية وانتفاخها والشعور بحرقة أثناء التبول. التهاب الأعضاء التناسلية للمرأة قد يسبب مرض الالتهاب الحوضي والذي -عن عدم معالجته- قد يؤدي للعقم. كما تسبب النيسرية البنية التهاب الملتحمة والتهاب البلعوم والتهاب المستقيم والتهاب الإحليل والتهاب البروستاتة والتهاب الخصية.
التهاب الملتحمة الناتج من النيسرية شائع لدى حديثي الولادة وعادة ما يتم استخدام المضادات الحيوية أو نترات الفضة للوقاية منها. وتنتقل العدوى للطفل أثناء مروره في مجرى الولادة، وقد يؤدي التهاب الملتحمة إلى تندب أو ثقب القرنية. انتشار البكتريا داخل الجسم قد يؤدي إلى التهاب الشغاف أو التهاب السحايا أو متلازمة التهاب الجلد والمفاصل النيسرية.
العلاج والوقاية
إذا كانت النيسرية البنية مقاومة للبنسيلين يستخدم الجيل الثالث من سيفالوسبورين مثل سيفترياكسون، كما يجب معالجة الشريك الجنسي واختبار الشريكان للأمراض المنقولة جنسياً كداء المتدثرات.
يمكن الوقاية من المرض عن طريق استخدام عازل ذكري والحد من عدد الشركاء الجنسيين.
انظر أيضًا
المراجع
- موسوعة الحياة (بالإنكليزية) EOL نيسرية بنية تاريخ الولوج 31 كانون ثاني 2018 نسخة محفوظة 02 فبراير 2018 على موقع واي باك مشين.
- Ryan KJ, Ray CG (editors) (2004). Sherris Medical Microbiology (الطبعة 4th ed.). McGraw Hill. ISBN 0838585299. الوسيط
|CitationClass=تم تجاهله (مساعدة)صيانة CS1: نص إضافي: قائمة المؤلفون (link) صيانة CS1: نص إضافي (link) - "Mighty microbe pulls 100,000 times its bodyweight". New Scientist. 19 April 2008. مؤرشف من الأصل في 02 أبريل 2015. اطلع عليه بتاريخ 01 يوليو 2009. الوسيط
|CitationClass=تم تجاهله (مساعدة); تحقق من التاريخ في:|تاريخ أرشيف=(مساعدة)
وصلات خارجية
صور وملفات صوتية من كومنز
أنواع من ويكي أنواع.
- بوابة بكتيريا
- بوابة علم الأحياء
- بوابة علم الأحياء الخلوي والجزيئي
- بوابة علم الأحياء الدقيقة